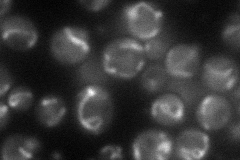
YIL114C
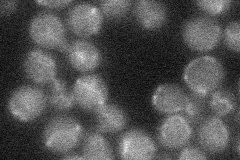
YIL114C
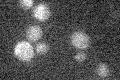
YIL114C

View description
Putative mitochondrial porin (voltage-dependent anion channel), related to Por1p but not required for mitochondrial membrane permeability or mitochondrial osmotic stability
Localization:
Intensity:
Fold change:
Significance:
-
C’ GFP library in SD

below threshold14.66 -
N' NOP1pr-GFP in SD
mitochondria50.916 -
N' TEF2pr-mCherry in SD

mitochondria12.5095 -
N' NATIVEpr-GFP in SD
mitochondria22.076 -
N' TEF2pr-VC and Cyto-VN in SD

#N/A0 -
C’ GFP library in SD+DTT

cytosol15.131.03No -
C’ GFP library in SD+H2O2

cytosol14.590.99No -
C’ GFP library in Starvation Media
cytosol16.421.11No -
C’ GFP library on the background of Pup2-DaMP

below threshold -
C’ GFP library on the background of CCT mutant

below threshold15.65361.06697No
